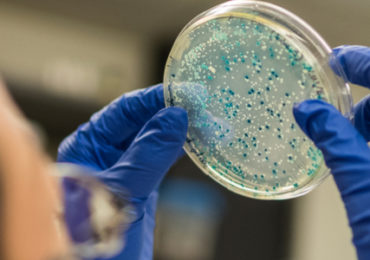
salmonella-kentucky-multiresistante-antibiotiques

1h par jour, 5 fois par semaine, ce n’est pas la mesure du temps passé devant les écrans, mais bien l’activité physique hebdomadaire nécessaire …
Un expert en vidéo: Herman Konings
Qu’ont en commun le manque de temps et le contenu de notra ssiette ou notre mode de vie? Bien plus que ce que l’on pourrait …
La Salmonella Kentucky, multirésistante aux antibiotiques
Une étude récente souligne l’émergence d’une salmonelle devenue résistante à presque tous les antibiotiques, et identifie la volaille comme le p…
Dernières évaluations des allégations
Ça y est, l’EFSA a enfin terminé l’évaluation des allégations de santé fonctionnelles génériques. Bilan de trois années de travaux des experts de l’Autorité…
La cuisine home made: do it yourself!
À la télévision comme sur internet, la cuisine crève l’écran. Amateurs et passionnés se retrouvent derrière les fourneaux. Le mot d’ordre: do it yourself…
Comment rééquilibrer la sédentarité des enfants?
1 heure par jour, 5 fois par semaine, ce n’est pas la mesure du temps passé devant les écrans, mais bien l’activité physique hebdomadaire nécessaire…
Viasano lance une nouvelle campagne: «Jouer, c’est déjà bouger»
L’objectif de la rentrée des classes pour Viasano est de faire bouger les enfants, de la façon la plus naturelle et spontanée qui soit, c’est-à-…
Le prix, toujours le premier critère d’achat alimentaire en 2011
Prix, qualité et fraîcheur seraient les critères d’achat de produits alimentaires les plus importants aux yeux de 78% des consommateurs. C’est c…
Recherche pionnière sur le microbiome intestinal
Tous les deux ans, le prestigieux Prix International de Nutrition de Danone soutient la recherche académique en nutrition humaine. Il récompense cette année…
Une application iPhone mesure la fraîcheur du poisson
« How fresh is your fish? » est l’intitulé de cette nouvelle application gratuite pour iPhone, qui détermine en quelques étapes la fraîcheur de votre …